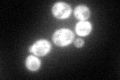
YGL031C
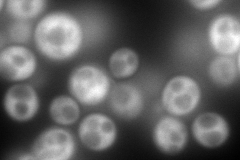
YGL031C
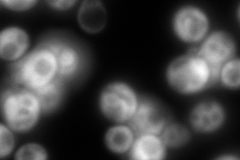
YGL031C
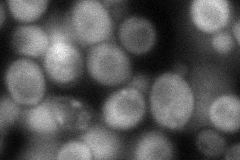
YGL031C
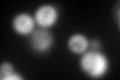
YGL031C
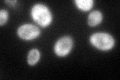
YGL031C

View description
Ribosomal protein L30 of the large (60S) ribosomal subunit, nearly identical to Rpl24Bp and has similarity to rat L24 ribosomal protein; not essential for translation but may be required for normal translation rate
Localization:
Intensity:
Fold change:
Significance:
-
C’ GFP library in SD
cytosol128.25 -
N' NOP1pr-GFP in SD
cytosol366.023 -
N' TEF2pr-mCherry in SD

cytosol6.28348 -
N' NATIVEpr-GFP in SD
cytosol680.151 -
N' TEF2pr-VC and Cyto-VN in SD
cytosol82.5621 -
C’ GFP library in SD+DTT
cytosol113.380.88No -
C’ GFP library in SD+H2O2

cytosol118.340.92No -
C’ GFP library in Starvation Media
cytosol189.841.48Yes -
C’ GFP library on the background of Pup2-DaMP

cytosol -
C’ GFP library on the background of CCT mutant

cytosol131.2461.02328No
